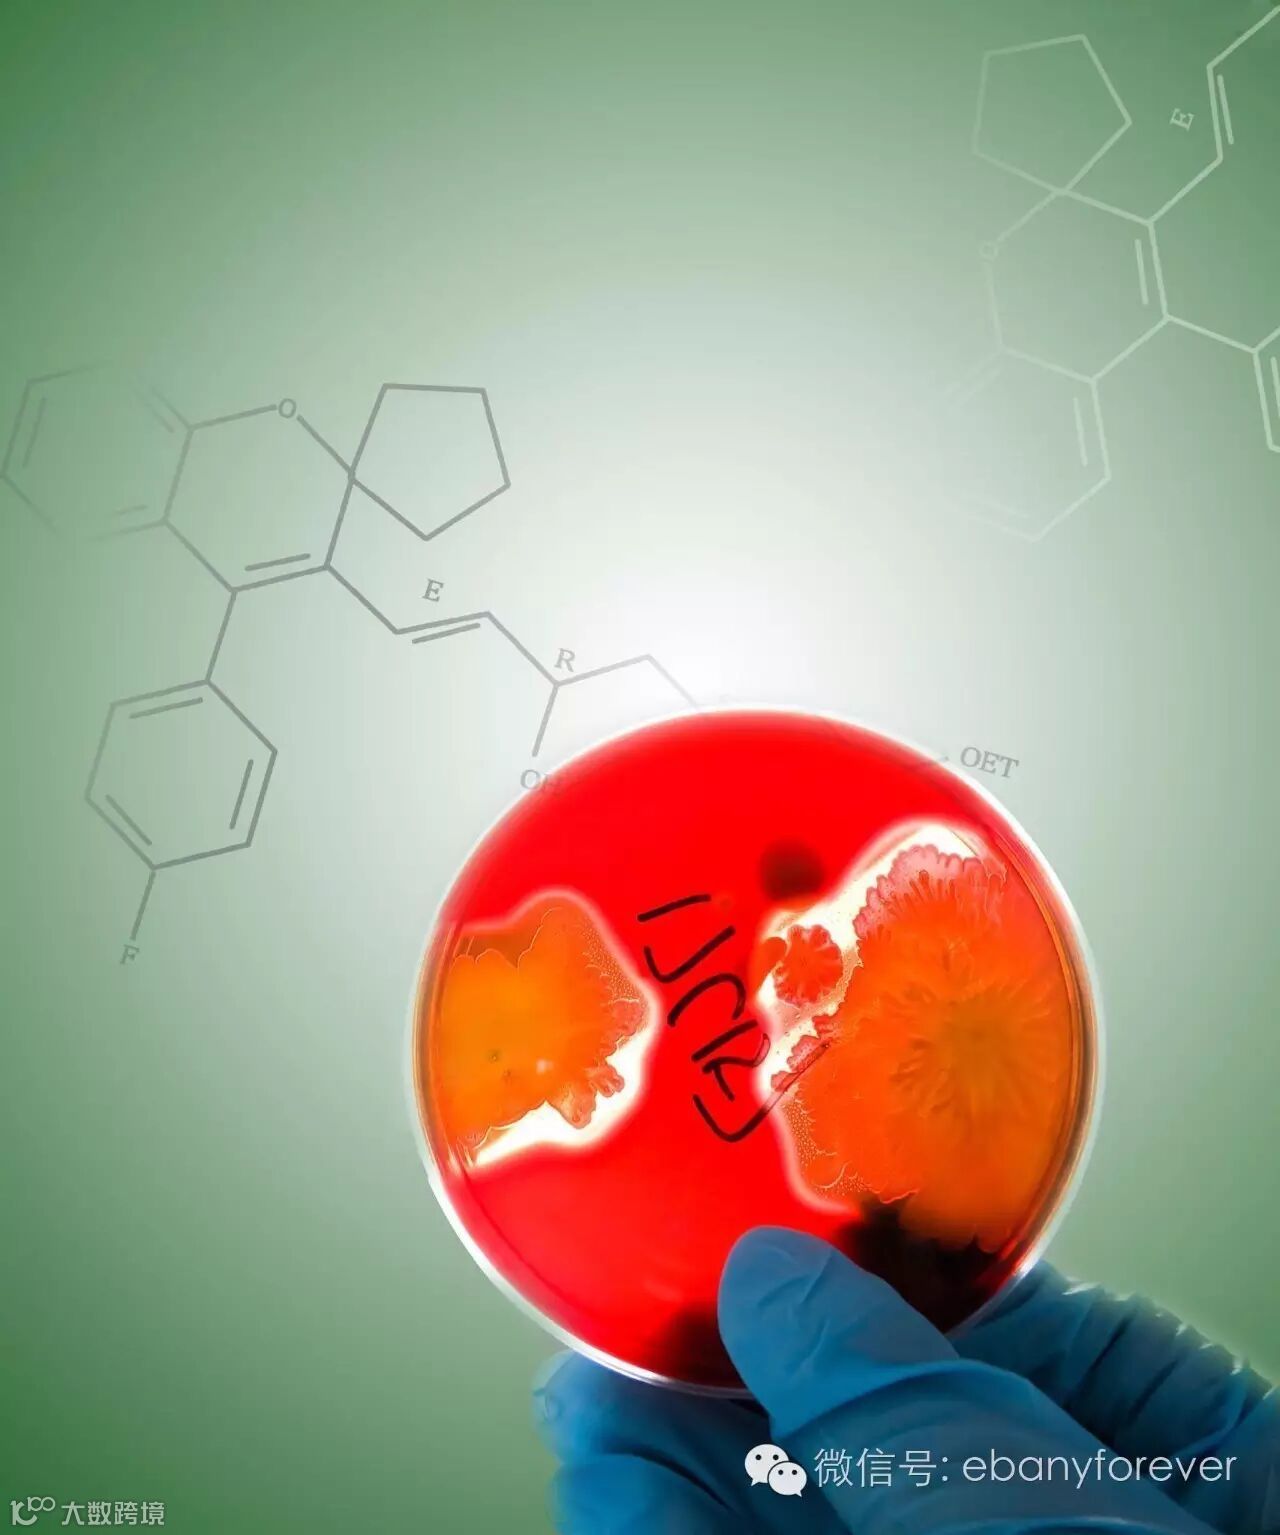

多事之秋又来了,这个时期宝宝很容易感染胃肠型细菌和病毒,导致腹泻,秋季宝宝腹泻,主要是因为轮状病毒入侵了宝宝稚嫩的胃肠道。
轮状病毒,是全世界范围内2岁以下婴幼儿严重腹泻最重要的病原,主要通过粪-口途径传播,四季均可感染,好发于秋冬季节。据统计,在发展中国家,5岁以下住院的腹泻患儿中有20%-50%是轮状病毒肠炎患者,每年导致约44万儿童死亡。
该病主要表现为:潜伏期1-3 天,起病急,常伴有发热和上呼吸道感染症状,起病初即发生呕吐,常先于腹泻;大便次数增多,多数每日在10次以内,亦可达数十次,量多,黄色或淡黄色,水样或蛋花汤样;为自限性疾病,病程约3-8天,可伴脱水和酸中毒症状。
郑州市第一人民医院曾选用江苏四环生产、荷兰DMV进口原料的亦贝安乳清乳铁蛋白胶囊做过一期临床实验,结论为乳铁蛋白对于轮状病毒有着确切的疗效。
乳铁蛋白治疗儿童轮状病毒肠炎疗效分析
【摘要】:目的探讨乳铁蛋白在治疗轮状病毒肠炎患儿中的疗效。方法:选用由江苏四环生产、荷兰DMV进口原料的亦贝安乳清乳铁蛋白胶囊,收集郑州市第一人民医院2013年9月~2014年3月住院部腹泻患儿的粪便标本210份,采用ELISA方法检测RV抗原,将轮状病毒阳性患儿118例随机分为观察组59例和对照组59例,对照组给予补液、补充微生态制剂、调整饮食等,观察组在对照组基础上加用乳铁蛋白口服,比较两组治疗有效率、症状缓解时间、住院时间及不良反应。结果观察组患儿总有效率94.9%(56/59),高于对照组的72.9%(43/59),差异有统计学意义(P<0.05);观察组患儿治疗效果、症状缓解时间、住院时间均优于对照组(P<0.05)。两组患儿均无严重不良反应发生。结论乳铁蛋白治疗轮状病毒肠炎患儿的疗效确切,不良反应较小。
【作者单位】:郑州市第一人民医院儿科;河南出入境检验检疫局;郑州人民 医院儿科;
【关键词】:轮状病毒 肠炎 儿童 乳铁蛋白
选自《中国现代医生》2015年35期

季节变换,抵抗力下降也是宝宝们普遍面临的问题。随之而来就是上呼吸感染,俗称感冒或上感,指鼻、咽和喉部以上部位的急性感染。
儿科专家崔玉涛指出,乳铁蛋白对于提高宝宝抵抗力,预防宝宝反复呼吸道感染效果显著。
《实用儿科临床杂志》第22卷第22期2007年11月发表的一篇《乳铁蛋白治疗反复呼吸道感染患儿的疗效》
目的:探讨乳铁蛋白对反复呼吸道感染(RRI)患儿免疫功能的影响。方法:选用江苏四环生产、荷兰DMV进口原料的亦贝安乳清乳铁蛋白胶囊,选取RRI患儿98例随机分为2组。对照组48例予常规治疗;观察组5O例在常规治疗基础上予乳铁蛋白治疗2~3个月。治疗前后分别测定患儿T细胞亚群、免疫球蛋白及补体等指标,观察其变化情况。
结果:2组总有效率分别为86%和22.9% 差异有非常显著性(P<0.005)。治疗后观察组免疫学指标CD3、CD4、CD4/CD8、IgG、IgA及IgM均明碌升高(P <0.O1,0.05),CD8较治疗前明显降低(P<0.05)。
结论:乳铁蛋白能增强反复呼吸道感染患儿的免疫功能,提高抗病能力。
乳铁蛋白组平均生病时间由原来的7-14天减少到3天;生病频率由原来的一个月一次,降低到3-6个月一次。
在这个特殊的季节,宝宝健康成长,减少生病,乳铁蛋白是您的最佳之选。


